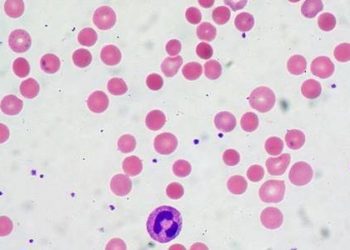
Complement mutation linked to poor response to eculizumab

#VisualAbstract: Iptacopan improves hematologic and clinical outcomes in paroxysmal nocturnal hemoglobinuria
1. In two clinical trials, iptacopan in patients with paroxysmal nocturnal hemoglobinuria (PNH) improved hemoglobin levels compared to anti-C5-treated patients ...